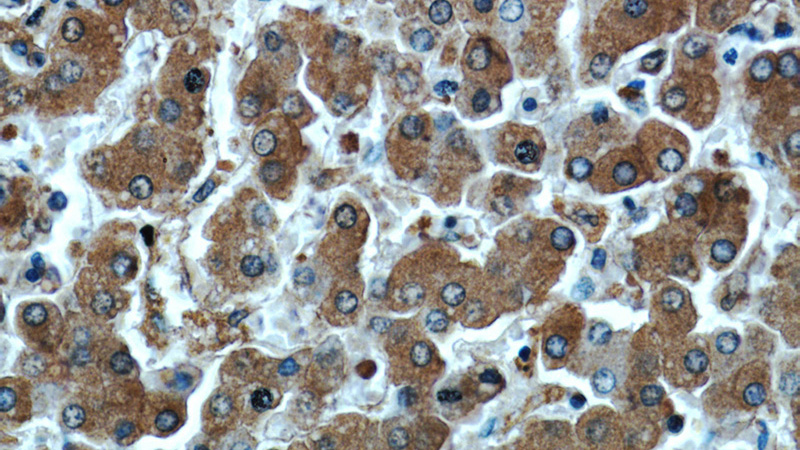
Immunohistochemical of paraffin-embedded human liver using Catalog No:107580(Alpha-1-Antitrypsin antibody) at dilution of 1:50 (under 40x lens)

-
Product Name
Alpha-1-Antitrypsin antibody
- Documents
-
Description
Alpha-1-Antitrypsin Mouse Monoclonal antibody. Positive IP detected in human plasma tissue. Positive WB detected in HepG2 cells. Positive IF detected in HepG2 cells. Positive IHC detected in human liver tissue. Observed molecular weight by Western-blot: 51 kDa
-
Tested applications
ELISA, WB, IHC, IF, IP
-
Species reactivity
Human; other species not tested.
-
Alternative names
A1A antibody; A1AT antibody; AAT antibody; Alpha 1 antiproteinase antibody; Alpha 1 antitrypsin antibody; Alpha 1 protease inhibitor antibody; PI1 antibody; PRO2209 antibody; PRO2275 antibody; Serpin A1 antibody; SERPINA1 antibody; SPAAT antibody; α1-antitrypsin antibody
-
Isotype
Mouse IgG1
-
Preparation
This antibody was obtained by immunization of Alpha-1-Antitrypsin recombinant protein (Accession Number: NM_001127700). Purification method: Protein G purified.
-
Clonality
Monoclonal
-
Formulation
PBS with 0.02% sodium azide and 50% glycerol pH 7.3.
-
Storage instructions
Store at -20℃. DO NOT ALIQUOT
-
Applications
Recommended Dilution:
WB: 1:500-1:5000
IP: 1:500-1:5000
IHC: 1:20-1:200
IF: 1:20-1:200
-
Validations

HepG2 cells were subjected to SDS PAGE followed by western blot with Catalog No:107580(Alpha-1-Antitrypsin antibody) at dilution of 1:1000

Immunohistochemical of paraffin-embedded human liver using Catalog No:107580(Alpha-1-Antitrypsin antibody) at dilution of 1:50 (under 10x lens)
Immunohistochemical of paraffin-embedded human liver using Catalog No:107580(Alpha-1-Antitrypsin antibody) at dilution of 1:50 (under 40x lens)

IP Result of anti-Alpha-1-Antitrypsin (IP:Catalog No:107580, 5ug; Detection:Catalog No:107580 1:1000) with human plasma tissue lysate 4000ug.

Immunofluorescent analysis of HepG2 cells using Catalog No:107580(Alpha-1-Antitrypsin Antibody) at dilution of 1:50 and Alexa Fluor 488-congugated AffiniPure Goat Anti-Mouse IgG(H+L)
-
Background
SERPINA1 is the gene for a protein called alpha-1-antitrypsin (AAT), which is a serine protease inhibitor whose targets include elastase, plasmin, thrombin, trypsin, chymotrypsin, and plasminogen activator. AAT is a glycoprotein synthesized primarily by hepatocytes, with smaller amountssynthesized by intestinal epithelial cells, neutrophils, pulmonary alveolar cells and macrophages. AAT is the most abundant, endogenous serine protease inhibitor in blood circulation and it has been implicated in regulating vital fluid phase biological events such as blood coagulation, fibrinolysis, complement activation, apoptosis, reproduction, tumor progression and inflammatory response. The primary function of AAT is thought to be the inactivation of neutrophil elastase and other endogenous serine proteases. Defects in SERPINA1 can cause emphysema or liver disease.
Related Products / Services
Please note: All products are "FOR RESEARCH USE ONLY AND ARE NOT INTENDED FOR DIAGNOSTIC OR THERAPEUTIC USE"
